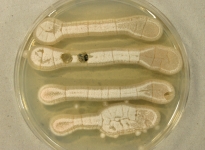
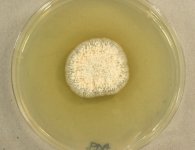

<< back to search
IMAGES:

Search Details
add to cart
| UAMH Number: | 4515 |
|---|---|
| Species Name: | Niesslia nordinii |
| Type: | |
| Synonyms: | Cephalosporium nordinii / Monocillium nordinii |
| Taxonomy: | FUNGI Ascomycota, Sordariomycetes, Hypocreales, Niessliaceae |
| Strain History: | A.Tsuneda -> Hiratsuka, Y. (C-690) -> UAMH |
| Substrate: | Endocronartium harknessii on Pinus contorta | Location: | CANADA British Columbia, Blue River (GEO: 52.115,-119.305) |
| Isolator: | A.Tsuneda |
| Isolation Date: | 1979-07-01 |
| Date Received: | 1982-02-22 |
| Characters: | CHEMOTAXONOMY survey for sterigmatocystin production - Rank C, Nielsen KF, Larsen TO, Varga J, Samson RA, Frisvad JC, Fungal Biology 115:406-420, 2011 // HYPERPARASITE destructive mycoparasite of the pine stem rust Cronartium coleosporoides and Endocronartium harknessii - Tsuneda A, Hiratsuka Y, Phytopathology 70:1103, 1980 // MESOPHILIC grow at 18 to 22C - // MOLECULAR SYSTEMATICS ITS sequence identical to Monocillium nordinii UAMH 11401 and 4810 - fide UAMH 2011 // PIGMENT yellow on PDA - (Click for publications citing UAMH 4515) |
| Compounds: | NORDINONE, NORDINONEDIOL, MONORDEN, MONOCILLINS I-IV, STERIGMATOCYSTIN Ayer WA, Pena-Rodriguez L, Phytochemistry 26:1353-1355, 1987 |
| Cross Reference: | |
| Collections: | Living Strains; Dried Herbarium Material |
| Pathogenic Potential: | Human: no | Animal: no | Plant: no |
| Biosafety Risk Group: | RG1 (check the PHAC ePATHogen Risk Group Database for updates) |
| Regulatory Requirements: | No restrictions for Canadian requesters. International requesters must provide all legally required importation documentation prior to shipment. Plant pathogenicity status may be verified by using the USDA Agricultural Research Service (ARS) Fungal Database |
| MycoBank ID: | 827293 |
| Sequences: | >UAMH04515_UAMH_ITS CATTACCGAGTTTACAACTCCCAAACCCCTGTGAACCATACCTATCGTTGCTTCGGCGGCCACGCCCCGGCGCCCTCGTGGCCCGGAACCAGGCGCCCGCCGGAGGACCCCAAACCATTGTGTGTTATAGCGGCATTATCTGAGTGACACAAACAAATAAATCAAAACTTTCAACAACGGATCTCTTGGTTCTGGCATCGATGAAGAACGCAGCGAAATGCGATAAGTAATGTGAATTGCAGAATTCAGTGAATCATCGAATCTTTGAACGCACATTGCGCCCGCCAGCATTCTGGCGGGCATGCCTGTTCGAGCGTCATTTCAACCCTCGCGCCCATCTGGGCTGCGGCGTTGGGGACCGGCACAACCGCCCTCCGGGGCGGCGCCGCCCCCCAAATATAGTGGCGGTCTCGCTGCAGCCTCCCTTGCGTAGTAGCACACCTCGCACTGGAGAGCGGCGCGGCCACGCCGTAAAACCCCCGACCCCCTTGAGTT |
IMAGES: